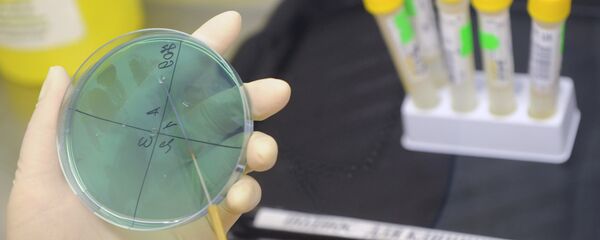
Работа лаборатории. Архив. Работа лаборатории. Архив. - Sputnik Кыргызстан

БИШКЕК, 20-мар. — Sputnik. Республикалык ветеринардык диагностика жана экспертиза борборунун химико-токсикология жана ветеринардык-санитардык экспертиза боюнча лабораториясы алгачкы аккредитациядан өттү. Бул туурасында Экономика министрлигини маалымат кызматы билдирди.
Лаборатория ИСО/МЭК 17025:2005 эл аралык стандартына ылайык каттоодон өттү.
Ветеринардык лабораторияны аккредитациядан өткөрүү бул сыноо лабораторияларын Бажы биримдигинин талаптарына даярдоо боюнча жасалып жаткан кадамдардын бири.
Ошондой эле Республикалык ветеринардык диагностика жана экспертиза борборунун вирусологиялык лабораториясын, андан сырткары Айыл чарба жана мелиорация министрлигинин алдындагы Өсүмдүктөрдү химизациялоо жана коргоо департаментинин Өсүмдүктөрдүн карантини боюнча борбордук лабораториясын аккредитациядан өткөрүү боюнча керектүү иштер жасалып жатат.